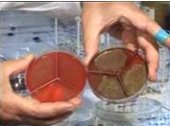

بسم الله الرحمن الرحيم
عشرون وصية للذابحين غدا

الحمد لله الذي بنعمته تتم الصالحات، وبعفوه يغفر الزلات، والصلاة والسلام على نبي المرحمات، محمد بن عبد الله وعلى آله وأصحابه أفضل الصلوات
كل عام وأنتم لله أ قرب، وتقبل الله منا ومنكم الصالحات والطاعات من صيام لغير الحجاج، ودعاء وصلاة وتقرب من كل المسلمين، ومن أضاحي للمضحين غدا بإذن الله.
أغتنم هذه الفرصة السعيدة الطيبة لأهدي لكل قارئ مضحياً هذا العام أو متمنياً على الله أن يوسع رزقه ليضحي في أعوام قادمة أتقدم اليهم جميعاً بمجموعة من التوصيات التي أدعو الله تعالى أن تنفعهم في معاشهم ومعادهم وأن يجعلها لي ذخرا في ميزان الحسنات اللهم آمين.
-
النفس الطيبة: قال عليه الصلاة والسلام:" لن ينال الله لحومها ولا دماءها ولكن يناله التقوى منكم، فطيبوا بها نفساً"، أي قدم الأضحية لله تعالى بنفس طيبة، واعلم أنها بأصوافها وأوبارها وأشعارها ولحمها وشحمها ودمها وثمنها كلها في ميزان حسناتك بإذن الله.
-
أطعم الأضحية حتى قبل موعد الذبح ب12 ساعة فاكتفي بعدها بالماء فقط، فإن لذلك تأثيرات طبية ينصح بها الأطباء على لحمها.
-
التسمية عند الذبح بصوت مرتفع تسمعه الأضحية ولحمها وشحمها وكل ما فيها يسمع ذكر الله، وذلك لعدة اعتبارات منها:
-
أن الله تعالى قال لنا:" فَاذْكُرُوا اسْمَ اللَّهِ عَلَيْهَا صَوَافَّ " ، ونهانا نهياً واضحاً بآية صريحة أن نأكل لحماً لم يذكر اسم الله عليه، فقال: "وَلاَ تَأْكُلُواْ مِمَّا لَمْ يُذْكَرِ اسْمُ اللّهِ عَلَيْهِ وَإِنَّهُ لَفِسْقٌ "
-
عند سماع الدابة لاسم الله فإنها تستسلم أكثر من كثير من البشر، وأعجب مقطع youtube على الاطلاق أراه في هذا المجال ما سأضع لك رابطه الآن فتشاهد بأم عينك ما سيحملك أن تستسلم لقوة كلمة "بسم الله الله أكبر" على نفس الحيوانات فتقول سبحان الله، والذي يذكرها مسلم لا ينطق بالعربية في لغته الأصلية، بل مؤمن بكل ما يقول، أدعو كل قارئ أن يدخل هذا الرابط لبرى بنفسه، فليس الخبر كالمعاينة ، الرابط هو :
http://www.youtube.com/watch?v=scknjGj5BbU&feature=related -
صحياً اللحم المستخرج من الدابة التي لم يذكر اسم الله عليه مملوء بالجراثيم كما موضح بالصورة من مختبرات الفحص المجهري .
بعد فحص قطعة لحم العينة "لحم الخروف المذبوح دون ذكر اسم الله عليه" نراه ممتلئاً بمستعمرات من الجراثيم العنقودية Staphylo coccus الضارة الفتَّاكة بصحة المواطنين..
بعد فحص قطعة لحم العينة "لحم الخروف المذبوح دون ذكر اسم الله عليه" نراه ممتلئاً بمستعمرات من الجراثيم العنقودية Staphylo coccus الضارة الفتَّاكة بصحة المواطنين..
لقد قامت هيئة صحية وطبَّقت التكبير على خمس ذبائح ذُكِرَ اسم الله عليها، وخمس خرفان أخرى لم يُذكر اسم الله عليها، وزرعت العينات المأخوذة من الذبائح الست لمدة ثمانٍ وأربعين ساعة فكانت النتيجة الطبية الصاعقة: إنَّ الخرفان التي لم يُذكر اسم الله عليها، كانت محتقنة بمستعمرات الجراثيم، عكس التي ذُكِرَ اسم الله عليها فكانت خاليةً إطلاقاً من الجراثيم،
-
إراحة الدابة: بإضجاعها على الأرض وليس وهي واقفة تذبح خلسة ومفاجأة، عـن أبي يعـلى شـداد بـن اوس رضي الله عـنه ، قال عليه الصلاة والسلام: " إن الله كتب الإحسان على كل شيء فإذا قتلتم فأحسنوا القتلة وإذا ذبحتم فأحسنوا الذبحة وليحد أحدكم شفرته وليرح ذبيحته " رواه مسلم (رقم : 1955)
-
اتجاه القبلة: أن يكون رأس الدابة في جهة يسار الذابح وهو متجه الى القبلة، وبقية جسمها عن يمينه، ثم يضع رجله اليمنى على صفاحها، ويمسك رأسها وفمها بيده اليسرى ويذبح باليمنى بعد الجهر بالتسمية، وليس الاسرار بها لان بعض الذابحين في غمرة الذبح والامساك بأرجل الدابة وحكمها ينسى التسمية وهي أهم قيد يريح الدابة فتستسلم.
-
ثلاث مصطلحات مهمة في تذكية الحيوانات كلها وردت في القرآن الكريم ،وهي:
-
الذبح: وهو قطع أربع قنوات وهي: الودجين (وهما مجرى الدم الواصل من القلب الى الرأس)، والقصبة الهوائية (مجرى التنفس)، والمرئ (مجرى الطعام) ، ومكان الذبح من العقلة (تفاحة آدم) لأن تجمع هذه القنوات عندها ينتهي، فيكون مكان الذبح الشرعي من عليها بالضبط أو أسفل منها في اتجاه الجسم حتى منطقة اتصال الرقبة بالجسم، أما فوق تفاحة آدم باتجاه الرأس فهذا ذبح غير شرعي، المعنى أن تبقى تفاحة آدم ملحقة بالرأس بعد الذبح وليس بالجسم. -
النحر: وهو قطع لبة الحيوان ذي الرقبة الطويلة كالجمل، وهي أول الرقبة من اتجاه الجسم فإن النحر للحيوان ذي الرقبة الطويلة أسرع لخروج روحه، وأكثر راحة له، قال تعالى: "فصل لربك وانحر".
-
العقر: وهو ضرب الحيوان في مكان قاتل عادة، كأن يهرب العجل فيضرب بالنار في رأسه بعد التسمية ، قال تعالى: "فعقروا الناقة وعتوا عن أمر ربهم".
-
لا تقطع الرأس: لان ذلك مخالف للسنة أولاً، ثم صحياً وطبياً الشاة المذبوحة بقطع الرأس نرى الدم يصب صباً، أما التي بقي رأسها متصلا بالجسم فنرى الدم يثعب متدفقاً ثاجاً سريعاً، والسر في ذلك أن بقاء المخ متصلا بالجسم سيصدر للقلب الأوامر بالنجدة للمنطقة التي قطعت وهي الودجان والرأس ، فتبدأ حالة الطوارئ في الجسم فيتجمع الدم من كل العروق وتتصفى الدابة بذلك من الدماء.
-
غسل اللحم بعد السلخ، والانتباه عند نزع المرارة، والسقيطة ألا يخرج منها ما يلوث اللحم، والمثانة والأعضاء المتصلة بها.
-
الأكياس المائية التي قد توجد في الرئة (الفشة) أو القلب والكبد تزال مباشرة، وليحذر الناس من العبث بها وخرقها وانزال الماء منها على الكبد واللحم في عبارة عن تجمع فطريات وجراثيم.

في الكبد أكياس مائية
يرقات الدودة الشريطية مرض طفيلي على شكل نقط بيضاء في الكبد وأكياس مائية بالوجه الداخلي للكبد أو في شحم الأمعاء، إذا كان العضو مملوءاً بالنقط البيضاء فلا تأكله، وإذا كانت الاصابة خفيفة فيمكن إزالتها وأكلها.

في القلب يرقات الدودة الشريطية
-
الدم المسفوح: هو الدم الذي خرج من الجسم الى الهواء، وهو رجس كما قال الله تعالى: "قُل لاّ أَجِدُ فِي مَآ أُوْحِيَ إِلَيّ مُحَرّماً عَلَىَ طَاعِمٍ يَطْعَمُهُ إِلاّ أَن يَكُونَ مَيْتَةً أَوْ دَماً مّسْفُوحاً أَوْ لَحْمَ خِنزِيرٍ فَإِنّهُ رِجْسٌ"، إذن انتبه لغسل السكين التي ذبحت بها ولا تستخدمها في السلخ وازالة الجلد وتقطيع اللحم الا بعد غسلها لتقليل التلوث.
-
تلوث الرئة بالدم الراجع عبر القصبة الهوائية عند الذبح يضع بعض الذابحين السكين امام الودج الأعلى وهو يثعب دما فيصب الدم في مدخل القصبة الهوائية عائداً إلى داخلها ويلوثها.
-
نفخ الشاة من أجل سلخها مرفوض طبياً.
بعد الذبح يكون التحلل من السنة بعدم مس الأظافر والشعر خلال العشر الأوائل، لذلك على كل مضحي ملتزم بهذه الشعيرة وسيشارك في السلخ وتقطيع اللحم أن يقص أظافره وينظف يديه قبل أن يضع يديه وهي متسخة بما لا يراه من كائنات تحت أظافره. -
أماكن تجمع زرقاء أو سوداء للابر في الكتف أو الساق

-
تنظيف مكان الذبح وازالة الدماء لئلا تصير مستنقع للذباب والجراثيم والأمراض.
-
دفن الأعضاء التالفة التي بها أمراض كالتي تكلمنا عنها من الدودة الشريطة والمياه المتكيسة، وعدم رميها للكلاب والقطط لأكلها لما لذلك من عدوى وأضرار كثيرة.
-
إخراج الكبد والقلب والرئة بسرعة حتى تضمن احتفاظها بأكبر قدر من الجودة.
-
يستهلك اللحم المخزن في مدة 3 أشهر على الأكثر.
-
الأضاحي المستوردة قد تصل بحكم المعابر وبعد المسافات في وضع غير مناسب صحياً واتلافها في هذه الحالة هو الحكمة.

وأخيراً: صحة وعافية


